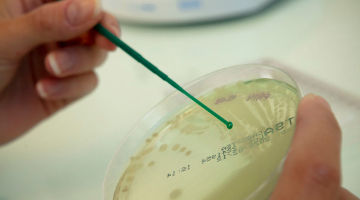

Effective synergy
As part of a team of experts to ensure:
- The development of new biological tools in immunology, molecular biology, cellular engineering
- Identification of new markers
- The development of analytical methods
- Scientific and technical support
- The quality of services and products developed and manufactured in-house
Main sectors of activity
- Pharmaceutical
- BioTherapeutics
- Biotechnology
- In vitro diagnostics
- Animal health
- Dermo-cosmetic
- Agribusiness
- Life sciences
- Environment
- Research Institutes